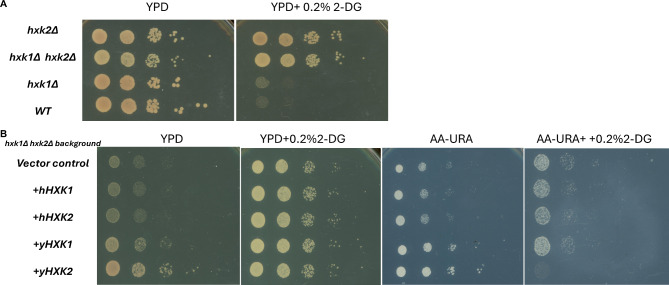
Fig. 1

Abstract
Background
Human hexokinase 2 (HK2) plays an important role in regulating Warburg effect, which metabolizes glucose to lactate acid even in the presence of ample oxygen and provides intermediate metabolites to support cancer cell proliferation and tumor growth. HK2 overexpression has been observed in various types of cancers and targeting HK2-driven Warburg effect has been suggested as a potential cancer therapeutic strategy. Given that epigenetic enzymes utilize metabolic intermediates as substrates or co-factors to carry out post-translational modification of histones and nucleic acids modifications in cells, we hypothesized that altering HK2 expression could impact the epigenome and, consequently, chromatin stability in yeast. To test this hypothesis, we established genetic models with different yeast hexokinase 2 (HXK2) expression in Saccharomyces cerevisiae yeast cells and investigated the effect of HXK2-dependent metabolism on parental nucleosome transfer, a key DNA replication–coupled epigenetic inheritance process, and chromatin stability.
Results
By comparing the growth of mutant yeast cells carrying single deletion of hxk1Δ, hxk2Δ, or double-loss of hxk1Δ hxk2Δ to wild-type cells, we firstly confirmed that HXK2 is the dominant HXK in yeast cell growth. Surprisingly, manipulating HXK2 expression in yeast, whether through overexpression or deletion, had only a marginal impact on parental nucleosome assembly, but a noticeable trend with decrease chromatin instability. However, targeting yeast cells with 2-deoxy-D-glucose (2-DG), a clinical glycolysis inhibitor that has been proposed as an anti-cancer treatment, significantly increased chromatin instability.
Conclusion
Our findings suggest that in yeast cells lacking HXK2, alternative HXKs such as HXK1 or glucokinase 1 (GLK1) play a role in supporting glycolysis at a level that adequately maintains epigenomic stability. While our study demonstrated an increase in epigenetic instability with 2-DG treatment, the observed effect seemed to occur dependent on non-glycolytic function of Hxk2. Thus, additional research is needed to identify the molecular mechanism through which 2-DG influences chromatin stability.
Supplementary Information
The online version contains supplementary material available at 10.1186/s13072-024-00551-9.
Keywords: Hexokinase, 2-deoxy-D-glucose, Histone chaperones, eSPAN, Chromatin replication, Yeast, Chromatin stability, Histone methylation, Histone acetylation
Background
Hexokinases (HKs or HXKs), the rate-limiting enzyme responsible for glucose metabolism [1], catalyzes the phosphorylation of glucose to glucose-6-phosphate (Glc-6-P). Glc-6-P subsequently enters glycolysis (triose phosphate pathway) or pentose phosphate pathway, serving as a vital substrate for adenosine triphosphate (ATP) production and the biosynthesis of various metabolites (amino acids, nucleic acids, and lipids). There are four HK isozymes (HK1-4) in humans [2]. And each has a different tissue and organ distribution, as well as distinct metabolic functions [3]. Expression of some HKs is associated with worse prognosis in several tumor types. For example, HK1 plays an oncogenic role in bladder cancer [4], and HK2 enhances live cancer stemness [5]. High HK2 expression has been linked to a variety kind of cancer and is associated with poor overall survival in cancer patients [6–8]. For these reasons, targeting HKs has been suggested as a potential strategy for cancer therapy [9, 10]. In support of this approach, deleting HK2 can decrease cancer cell proliferation without prominent side effects in animal models, suggesting HK2 is a promising target for cancer therapy [7]. Highly glycolytic proliferating cells, such as cancer cells, rely on HK2 expression to accelerate glucose metabolism, even under hypoxemia conditions. However, this hightened metabolic activity leads to the generation of metabolic products such as acetyl-coenzyme A (Acetyl-CoA), which serve as substrates for numerous epigenetic modulators, fulfilling both the energy needs of the cells and influencing chromatin modifications. Additionally, there is evidence suggesting that yeast Hxk2 translocate into the nucleus, potentially influencing gene expression, and cell differentiation [11, 12]. To learn more about the utility of targeting HKs, it is important to characterize the effects of modulating HK expression on eukaryotic cells.
In this study, we investigated how abnormal yeast Hexokinase 2 (HXK2) expression affects epigenetics and chromatin instability in a simple, genetically tractable model system for eukaryotic cell function: the budding yeast Saccharomyces cerevisiae. In this organism, three genes encode proteins that phosphorylate glucose to Glc-6-P: HXK1, HXK2, and the glucokinase gene GLK1. HXK2 appears to play the main role in glucose phosphorylation in vivo [13, 14]. Therefore, we investigated the effects of HXK2 deletion and overexpression on parental histone H3-H4 transfer, an essential step in epigenetic inheritance [15]. We hypothesized that the DNA-replication coupled epigenetic inheritance process is altered because DNA replication is an energy consuming process. We discovered that both kinds of modified HXK2 expression seemed to lessen chromatin instability and had only a little impact on the parental histone H3-H4 distribution on replicating chromatin. On the other hand, yeast chromatin instability was elevated by 2-deoxy-D-glucose (2-DG), a clinical glycolysis inhibitor that has been used as a cancer treatment [14]. Although 2-DG interacts with multiple cellular pathways and has various biological effects [16–18], 2-DG most well-known mechanism is related to glycolysis. Once inside the cell, 2-DG is phosphorylated by HXKs to form 2-deoxy-d-glucose-6-phosphate (2-DG-6-P), which, unlike G-6-P, cannot be further metabolized. This leads to the accumulation of 2-DG-6-P, resulting in product inhibition of hexokinase and subsequent inhibition of glycolysis [17].
Materials and methods
Yeast strains, plasmids, and growth conditions
S. cerevisiae yeast strains were grown in YPD (2% peptone, 1% yeast extract, 2% glucose) or yeast nitrogen base minus uracil (AA-Ura) media, to prevent plasmids loss at 30 °C [19]. Yeast strains used in this study are listed in Supplemental Table 1. Plasmids were transformed into yeast strains using the standard lithium acetate transformation method [20]. AA-Ura or YPD plates containing 2% glucose were supplemented with 0.2% w/v 2-DG. To prevent plasmid loss and ensure that only vector-containing cells can grow, yeast strain transformants are grown on selective media (AA-URA).
Mammalian cell culture
Human prostate cancer cell line, PC-3 cells were cultured in F-12 K Medium (Kaighn’s Modification of Ham’s F-12 Medium) supplemented with 10% Fetal Bovine Serum (FBS) and 1% penicillin-streptomycin. All cells were cultured in 37 °C, 5% CO2 incubator.
HXK cloning and yeast strain construction
To amplify yHXK1 and yHXK2 from yeast genomic DNA, we employed specific primer pairs (Kpn1-HXK1/Xba1-HXK1 and Kpn1-HXK2/Xba1-HXK2; primer sequences provided in Supplemental Table 2). Following amplification, the resulting DNA fragments were gel-purified using a Qiagen gel purification kit and subsequently cleaved with Kpn1 and Xba1 restriction enzymes. The resulting fragments were inserted into the yeast expression vector PSF-TEF1-URA3 (OGS534, Milipore-Sigma) at the corresponding restriction enzyme sites.
The yeast-codon optimized human HK genes hHK1 and hHK2 were synthesized directly, with the sequences described in the Supplemental Data. These gene fragments were enzymatically cut using the restriction enzymes EcoRV and XhoI and integrated into the PSF-TEF1-URA3 vector, utilizing the matching restriction enzyme sites.
To introduce the HXK-containing vectors and vector controls into yeast, we followed the standard lithium acetate transformation protocol. Colonies were selected on yeast synthetic complete supplement mixture minus uracil (SC-Ura) plates.
ATP measurements
Yeast cells (2 OD units at 600 nm) were collected in a 1.5 ml microcentrifuge tube by centrifugation at maximum speed for 1 min and washed once with cold distilled water. The supernatant was removed, and 0.75 ml of 90% acetone was added to the pellet. The resuspended cells were then heated at 90 °C for 15 min to allow the acetone to evaporate, leaving approximately 50 µl of solution. Assay buffer (10 mM Tris, pH 8.0, and 1 mM EDTA) was added to bring the final volume to 500 µl. ATP concentration was measured using the ATP Determination Kit (A22066, Thermo Scientific Inc.) according to the manufacturer’s instructions, with a luminescence microplate reader (BioTek U.S.).
Immunoblotting assay
To monitor the levels of histone marks in yeast strains, we performed whole cell extraction using tris-buffered saline (20 mM Tris pH 7.5, 150 mM NaCl) with protease inhibitor (phenylmethylsulfonyl fluoride PMSF). Briefly, log-phase cells (5 OD600) were harvested by spinning cultures at 5000 rpm (revolutions per minute) then washing the pellets with water, heating them at 95° C for 3 min, and suspending them in 50 ul tris-buffered saline buffer with 2 mM PMSF. Cells were physically broken by glass bead–beating them for 2 cycles (30 s per cycle). Proteins were then solubilized in 50 ul 2x SDS sample buffer [Tris-Cl (pH 6.8), 4% (w/v) sodium dodecyl sulfate (SDS; electrophoresis grade), 0.2% (w/v) bromophenol blue, 20% (v/v) glycerol]. Insoluble debris was separated from supernatant and removed by spinning the samples at the 15,000 g speed. To prepare mammalian cell lysates, cells were washed with 1x PBS and cells were resuspended in RIPA buffer (50 mM Tris-Cl (pH 8.0), 150 mM sodium chloride, 1% NP-40, 0.5% deoxycholate, 0.1% SDS). Protease inhibitors were added and kept on ice for 10 min. Soluble proteins were extracted by high-speed centrifugation. Soluble proteins (the supernatant) were separated by SDS-PAGE, transferred to nitrocellulose membrane (Bio-Rad 1620115) using Tris-Glycine buffer and probed with different primary antibodies [anti-γ-H2A antibody (ab15083 Abcam), tubulin (6A204 Santa Cruz), human hexokinase 2 (C64G5 Cellsignaling), H3K4me3 (ab8580 Abcam), Anti FLAG (F1804 Sigma), H3K36me3 (ab9050 Abcam), H3K56Ac (mc1681 provided by Dr. Zhiguo Zhang [21]), Sir2 (provided by Dr. Zhiguo Zhang) [22], H3K27Ac (07-360 Millipore), and H3K5,8,12Ac (C15410021 Diogenode), Hexokinase 2 (NBP2-44234, Novusbio), PGK1 (22C5D8 Abcam)]. The stain-free gel or Sir2, PGK1 is used as the loading control. The second antibody is either goat anti rabbit IgG HRP (AB_2337913, Jackson Immnoresearch) or goat anti mouse IgG HRP (AB_10015289, Jackson Immnoresearch). Immunoblots were developed by using Chemiluminescent Substrate (PI37069, Thermo-Scientific)and images were acquired using Bio-Rad Chemidoc (12003154, Bio-Rad).
Cell cycle analysis
Yeast strains were grown in YPD medium at 30° C until the cells reached mid-log phase (∼ 0.6 OD at 600 nm), at which time they were treated with 2-DG (0.2% w/v). A total of ∼ 1 × 107 cells were harvested at various time points by centrifugation, washed with water, and fixed with 95% ethanol overnight at 4° C. Fixed cells were collected by centrifugation, washed with 50 mM sodium citrate buffer (pH 7.5), and resuspended in 500 µL sodium citrate buffer (pH 7.5) with RNAase A (0.025 mg/mL). After cells were incubated for 1 h at 50° C, 25 µL proteinase K (20 mg/mL) was added to the cell suspension and the mixture was incubated at 50° C for another hour. Cells were subsequently stained overnight at 4° C using propidium iodide at a final concentration of 0.02 mg/mL. Finally, samples were analyzed in a fluorescence-activated cell sorting (FACS) flow cytometer (BD Fortessa cytometer). A minimum of 50,000 cells per sample were acquired.
Analysis of silencing-loss at the HML (HoMothallism Left) locus using the CRASH assay
The yeast strains WT (cyc1250), hxk2Δ (cyc1253), WT + PSF-yHXK2 (cyc1247), and hxk2Δ + PSF-yHXK2 (cyc1251) were used to measure the apparent silencing-loss rate at the HML locus. Briefly, 10 colonies of each strain were grown separately overnight in SC media, diluted to 0.01 OD at 600 nm in SC media, and grown for 5 h at 30° C. Cells were treated with 20 µM nicotinamide for the green fluorescent protein (GFP) + control; cells were grown in hygromycin (200 µg/ml) for the red fluorescent protein (RFP) + control. The apparent silencing-loss rate at the HML locus was calculated by dividing the number of RFP + GFP + cells (cells that have recently undergone Cre-mediated recombination express GFP but not RFP) by the total number of cells with the potential to lose silencing (RFP + GFP- and RFP + GFP+). For each colony, 50,000 events were analyzed using a BD Fortessa cytometer.
Enrichment and sequencing of protein-associated nascent (eSPAN)
The yeast strains WT (cyc1023), hxk2Δ (cyc1025), WT + PSF-HXK2 (cyc1022), and hxk2Δ + PSF-HXK2 (cyc1024) were used in this experiment. Briefly, yeast cells were grown in SC-URA- medium to exponential growth phase (∼ 0.5 OD at 600 nm). Two doses of α factor (5 µg/ml; EZBiolab) were added for 3 h at 25° C to arrest cell growth at the G1 phase. Cells were washed twice with cold water and then released into fresh YPD medium containing 400 mg/L Bromodeoxyuridine (BrdU) and 200 mM hydroxyurea for 45 min at 30° C. Hydroxyurea stalls the replication fork but does not interfere with assembly of newly synthesized and parental histones [23–25].
Cells were fixed by adding freshly prepared paraformaldehyde (final concentration 1%) at 25° C for 20 min, followed by quenching with 0.125 M glycine for 5 min at room temperature. After fixation, cells were washed twice with cold water and collected by centrifugation at 3000 rpm for 5 min. For chromatin immunoprecipitation (ChIP), cells were washed and lysed in 0.1 ml ChIP lysis buffer [50 mM HEPES (pH 8.0), 150 mM NaCl, 2 mM EDTA, 1% Triton X-100, 0.1% sodium deoxycholate] with glass beads. Broken cells were collected and washed twice with NP buffer [1.6 M sorbitol, 2 mM CaCl2, 5mM MgCl, 50 mM NaCl, 14 mM b-mercaptoethanol, 10 mM Tris-HCl (pH 7.4), 0.075% NP-40, 5 mM spermidine]. Chromatin was digested primarily to di- and mononucleosomes using the proper amount of MNase (LS004797, Worthington, ∼ 1 unit) at 37° C for 20 min. The digestion was terminated with 5 µl 0.5 M EDTA and 90 µl 5X ChIP lysis buffer and kept on ice for 30 min. Next, cells were lightly sonicated for five cycles (Bioraptor Pico machine, 30 s ON/OFF) at 4 °C to release chromatin fragments into solution. Soluble chromatin was immunoprecipitated with anti-H3K4me3 antibody (ab8580 Abcam) [21]. Prewashed Protein G Sepharose beads (17-0618-02, GE Healthcare) were used to recover the immunoprecipitated chromatin. After washing the beads extensively, ChIP DNA was recovered using the Chelex-100 protocol [15, 26–28].
ChIP DNA was denatured by incubating it at 100° C for 5 min and then on ice for 5 min. DNA was diluted with BrdU IP buffer [1X PBS, 0.0625% Triton X-100 (v/v)]. BrdU antibody (0.17 µg/ml; 555627, BD Biosciences) was added, and samples were incubated at 4° C for 2 h. Next, 20 µl prewashed Protein G beads (17-0618-02, GE Healthcare) were added to each sample and incubated for an additional hour at 4° C. The beads were extensively washed, then DNA was eluted with 100 µl 1X TE buffer containing 1% SDS and purified using a QIAGEN MinElute PCR Purification kit. Single-stranded DNA libraries were prepared using an Accel-NGS 1 S Plus DNA library kit (10096, Swift Biosciences).
Sequence mapping and data analysis
Sequence mapping, nucleosome mapping, and eSPAN analysis were performed similarly to what has been previously described [23, 24]. Briefly, reads were mapped to the Saccharomyces Genome Database (http://www.yeastgenome.org/) reference genome with Bowtie2 software [29]. Only paired-end reads with both ends mapped correctly were selected for continued analysis. We determined nucleosome occupancy using 120–170 bp DNA fragments calculated from paired-reads, using Python programs we developed ourselves. To calculate the eSPAN bias pattern, we separated forward (Watson strand) and reverse (Crick strand) reads following the reference genome. Nucleosome positions around DNA replication origins were determined previously [30]. Total eSPAN sequence reads at ± 10 nucleosomes surrounding the DNA replication origins were counted. The log2 ratio of Watson over Crick strand reads at each nucleosome position was used to obtain the average eSPAN bias pattern.
Western blot to detect yeast Rad53-P and γH2AX
The sample collection and process with Rad53-P and γH2AX followed previous publication [31]. Blotting was then performed with anti- Rad53 antibody (ab104232, Abcam) and γH2A.X (phospho S139) (ab11174 Abcam).
Results
Human HK1 or HK2 cannot complement yeast HXK deletion mutant as determined by yeast cell growth and 2-DG toxicity
In yeast, two HXKs, HXK1 and HXK2, and one glucokinase (GLK1) phosphorylate glucose, the first irreversible step in the intracellular metabolism of glucose [11]. Among these three enzymes, HXK2 is the dominant player in cell growth, as evidenced by the slow growth phenotype exhibited by hxk2Δ and hxk1Δ, hxk2Δ mutant cells; the growth of hxk1Δ cells is comparable to that of wild-type (WT) cells (Fig. 1A, left). Importantly, as shown previously [32], the glucose metabolic inhibitor 2-DG readily targets Hxk2 but not Hxk1 (Fig. 1A, right). This conclusion was based on the observation that the 2-DG show more toxic effect on hxk1Δ cells, than in hxk2Δ cells (Fig. 1A, right).
Fig. 1.
In yeast, HXK2 is the dominant hexokinase; overexpressing yeast HXK1 or HXK2, but not human HK1 or HK2, complements the slow cell growth phenotype in yeast cells lacking HXK1 or HXK2. (A) Ten-fold serial dilutions of yeast cells of the indicated genotypes were plated onto YPD medium with or without 0.2% 2-deoxy-D-glucose (2-DG, an HXK2 inhibitor). This result suggests that HXK2 is the dominant player in glucose metabolism. (B) Yeast HXK1 or HXK2 can complement the cell growth phenotype in hxk1Δ hxk2Δ cells, but human HK1 and HK2 cannot. Ten-fold serial dilutions of yeast cells of the indicated genotypes were plated onto YPD medium with or without 0.2% 2-DG (nonselective for the plasmid containing the HXK genes) and AA-URA medium with or without 0.2% 2-DG (selective for the plasmid). These results indicate that 2-DG is more specifically toxic towards targeting HXK2 than HXK1 because Hxk2 has a higher affinity to 2-DG than glucose (Glc), but Hxk1 has a higher affinity to Glc [32]
To investigate the effects of HXK expression, we overexpressed both yeast HXKs (yHXK1, yHXK2) and their human orthologs (hHK1, hHK2) in hxk1Δ hxk2Δ double mutant yeast cells. The HXK genes were placed under the control of the yeast constitutive TEF1 promoter [21] in a plasmid, and we grew each transformed strain under conditions that selected for the plasmid (AA-URA medium) and did not select for the plasmid (YPD medium). We hypothesized that expressing both human and yeast versions of the HXK genes could complement the slow growth phenotype of hxk1Δ hxk2Δ double mutant. Surprisingly, overexpressing human HKs in the yeast mutants cultured in YPD or AA-URA media had no discernible impact on yeast proliferation relative to vector-only control yeast (Fig. 1B). This outcome strongly suggests that human HK1 and HK2 do not function effectively in yeast cells. By contrast, expression of yeast HXK1 and HXK2 exhibited a complementary effect on yeast proliferation, evident in both YPD and AA-URA media (Fig. 1B). A plausible explanation for the lack of function of human hexokinases in yeast is the feedback inhibition by Glucose-6-Phosphate (Glc-6-P). Unlike yeast hexokinases, which are inhibited by Trehalose-6-Phosphate (T6P), human hexokinases are sensitive to inhibition by Glc-6-P [33]. At here, we want to explain a little about the media difference. Because cells could frequently lose the vectors (HXKs-containing or empty control) during proliferation process, the cells on the non-selective media (YPD) are mixture of cells with or without vectors. On the selective media (AA-URA), only vectors containing cells can grow.
Next, we investigated the toxic effect of 2-DG on overexpressed HXKs. The purpose is to further test the 2-DG’s specificity on the Hxks. When the transformed yeast strains were cultured on YPD supplemented with 0.2% 2-DG (non-selective media with a glucose metabolic inhibitor), no significant differences in proliferation were observed relative to the vector control strain. The loss of the transformed plasmid in the non-selective conditions is the cause of this finding. The strains were cultivated on AA-URA + medium supplemented with 0.2% 2-DG (selective media with an inhibitor of glucose metabolism). Because Hxk2 is more active than Hxk1, the inhibitory effect of 2-DG was more specific to cells containing yHXK2 than yHXK1(Fig. 1B). This finding emphasizes the critical function of yeast HXK2 in glucose metabolism and the inhibitory action of 2-DG on yHxk2p.
Impact of HXK2 expression on global histone modification levels
Overexpression of HXKs can result in the production of additional metabolic byproducts, such as acetyl-coenzyme A (Acetyl-CoA). Acetyl-CoA acts as a substrate for histone acetylation modifications, potentially resulting in changes to chromatin structure [34, 35]. To explore the relationship between HXK2 expression and the chromatin structure/epigenome, we employed four yeast strains characterized by varying HXK2 expression levels (ranked highest to lowest): WT + HXK2, hxk2Δ + HXK2, WT, and hxk2Δ (Fig. 2). First, we confirmed that expression levels for the strains were as expected (Fig. 2A). While overexpression of yeast HXK2 in the WT strain appeared to have no beneficial effect on cell proliferation under the used growth conditions, it significantly increased proliferation in the hxk2Δ yeast strain (Fig. 2A on AA-URA plate), indicating complementation hxk2Δ. The results are consistent with our former observation that the yeast HXK2 expression can complement the yeast hxk1Δ hxk2Δ (Fig. 1).
Fig. 2.
Impact of HXK2 expression on yeast cell growth and total histone modification levels. In this panel, we confirm the HXKs expression level by western blot and test HXKs level on total histone modification levels. (A) Cell growth rate of WT, WT + HXK2, hxk2Δ + HXK2, and hxk2Δ yeast strains. Ten-fold serial dilutions of yeast cells were plated onto YPD medium and AA-URA (conditions selective for the vector containing cells) with or without 0.2% 2-deoxy-D-glucose (2-DG, an HKs inhibitor) medium. The purpose of these dot assay is phenotype confirming of the genotypes. (B)Histone modification (H3K36me3, H3K27Ac, H3K4me3, H3K56Ac and H4K5,8,12Ac) levels by Western blot analysis. The expression levels of the four yeast strains were determined using a yeast HXKs-specific antibody. This antibody recognizes both Hxk2 and Hxk1, as illustrated in Fig. 3C. The exposure growth cells on AA-URA medium were collected for Western blot analysis
Next, we conducted immunoblot analysis to assess the effects of HXK2 expression on global histone modifications, as well as the abundance of the major chromatin silencing protein, Sir2, in the four yeast strains [13]. We examined modifications such as H3K36me3 (associated with active transcribed genes), H3K27Ac (associated with active gene transcription), H3K56AC(linked with DNA replication), and H4K5AC (linked to active gene transcription) [36]. Given that HXK2 serves as the rate-limiting enzyme in glucose metabolism and that acetyl-CoA is one of its primary substrates, it’s noteworthy that acetyl-CoA is also a crucial substrate for histone acetylation modifications. Considering this, HXK2 expression level may affect the epigenome, which may show different histone modification levels. However, no substantial differences were detected in the levels of these histone marks or in the abundance of Sir2 across the four yeast strains (Fig. 2B). This finding indicates HXK2 expression does not exert global effects on histone tail modifications. It is important to note, however, that these results do not rule out the possibility of specific changes in histone modifications at a particular region, warranting further investigation into the potential context-dependent impact of HXK2 on histone modifications.
Impact of HXK2 expression on parental histone transfer
One crucial aspect of stable epigenetic inheritance is the successful replication of epigenetic information during DNA replication. Nucleosome assembly, including the appropriate transfer of both parental (recycled histones from mother DNA strand) and newly synthesized histones (de nova synthesized histone), plays a pivotal role in establishment of both euchromatin (transcriptionally active regions) and heterochromatin (transcriptionally silent regions). Given the fundamental step in epigenetic regulation, we investigated whether HXK2 expression influences parental histone transfer and assembly. In WT yeast, parental H3-H4 tetramers are normally distributed nearly evenly between the leading and lagging strands of DNA replication forks, with a slight bias toward the lagging strand [23]. To assess the impact of HXK2 expression on parental histone distribution, we conducted an eSPAN assay, employing H3K4me3 as a marker for parental H3-H4 histones, as in our previous studies [15, 37]. Briefly, yeast cells were synchronized at the G1 phase and released into early S phase in the presence of BrdU and hydroxyurea. Cell harvesting occurred 45 min after release (Fig. 3A). Throughout the cell culture process, we employed selective culture medium (AA-URA) to prevent the loss of the HXK2-containing plasmid. FACS analysis of DNA content confirmed the effectiveness of our cell synchronization procedure (Fig. 3B, C), and Western blot analysis confirmed the well-controlled expression of HXK2 (Fig. 3D). In the hypothesis, we would expect to observe the changes of parental histone distribution pattern on the two replicating strands by eSPAN analysis.
Fig. 3.
Parental histones transfer experimental procedure: H3K4me3 eSPAN (enrichment and sequencing of protein-associated nascent DNA) analysis. (A) Procedure for monitoring the deposition of parental (H3K4Me3) histones at early DNA replication origins in yeast. (B-C) Fluorescence-activated cell sorting (FACS) analysis monitoring cell cycle progression in WT, WT + HXK2, hxk2Δ + HXK2, and hxk2Δ yeast strains. The FACS data indicate that the cell synchronization procedure for eSPAN analysis works well. (C) Histograms showing the distribution in the different phases of the cell cycle. (D) Western blot analysis monitoring HXK and H3K4me3 levels in the yeast strains from (B). The log phase hxk1Δ hxk2Δ strain sample serves as a negative control for the Hxk antibody
H3K4me3 ChIP, BrdU-IP-ssSeq, and H3K4me3 eSPAN sequence data were mapped to both the Watson and Crick strands of the yeast reference genome. No substantial differences were observed among the four strains for H3K4me3 ChIP and BrdU-IP-ssSeq data at typical mapping sites, such as ARS1309 (Fig. 4A and B). H3K4me3 eSPAN peaks at ARS1309 (Fig. 4C) displayed a nearly symmetric bias pattern, with a slight preference for the lagging strand in all four yeast strains. These findings suggest that parental histones H3-H4 were distributed in a nearly symmetrical manner between the leading and lagging strands at hydroxyurea-stalled replication forks, regardless of HXK2 expression levels.
Fig. 4.
Parental histone H3 (H3K4Me3) eSPAN (enrichment and sequencing of protein-associated nascent DNA) analysis at different HXK2 expression levels. A snapshot of parental histone (A) H3 (H3K4me3) chromatin immunoprecipitation (ChIP), (B) BrdU-IP-ssSeq, and (C) H3K4me3 eSPAN read enrichment at the early replication origin ARS1309 for the WT, WT + HXK2, hxk2Δ + HXK2, and hxk2Δ yeast strains. Sequence reads were mapped to both the Watson (red) and Crick (green) strands of the reference genome. We did not observe any obvious difference in the BrdU IP-ssSeq, H3K4me3 ChIP-seq and eSPAN. (D-G) Average bias ratio of parental histone H3 (H3K4Me3) for the WT, WT + HXK2, hxk2Δ + HXK2, and hxk2Δ yeast strains. Top: Average bias ratio of H3K4Me3 eSPAN peaks at each of the 10 nucleosomes surrounding the 134 early replication origins in the yeast genome. Bottom: Heatmaps representing the bias ratio of the same H3K4Me3 eSPAN peaks. Individual nucleosome positions (− 10 to + 10) are indicated relative to the origin. Each row represents the average log2 Watson/Crick ratio of H3K4Me3 eSPAN sequence reads at one origin
To determine whether the results we obtained at ARS1309 were characteristic of replication origins around the genome, we calculated the average strand bias ratio of H3K4me3 eSPAN peaks surrounding all 134 early DNA replication origins in yeast. The average bias ratio reflects the relative abundance of histones on the leading vs. lagging strand. Consistent with our findings for H3K4me3 eSPAN data at ARS1309 (Fig. 4C), all four strains exhibited a bias toward the lagging strand at these early DNA replication origins, regardless of HXK2 expression levels (Fig. 4D-G). However, we did observe significant variation in the average strand bias ratio at different nucleosome locations around the replication origins, particularly in the hxk2Δ strain (Fig. 4F, G). This variability may be attributable to differences in cell growth rates or low BrdU incorporation rates, factors that can significantly influence eSPAN bias calculations [37]. Overall, we conclude HXK2 expression has only a minor effect on the parental histone transfer process.
Effect of HXK2 expression and inhibition on chromatin stability
Even the HXK2 expression level does not have any clear impact on the parental histone transfer process by, it could affect the chromatin stability by other ways. To test this possibility genetically, we performed a well-established CRASH (Cre-reported altered states of heterochromatin) assay to monitor the transient loss of heterochromatin silencing at the HML locus. In this assay, the Cre recombinase gene is inserted into the transcriptionally silent HML locus. This assay allows for the detection of temporary loss of gene silencing at the HML locus by observing the expression of the Cre gene, which causes site-specific recombination at LoxP sites. This results in yeast strains exhibiting GFP sectors. Loss of gene silencing at HML locus leads to an increase in switch from RFP to GFP.
Flow cytometry analysis was utilized to quantify the rate of silencing loss in each of the four yeast strains (Figs. 2, 3 and 4). We hypothesized that overexpression or deletion of HXK2 changes chromatin stability because of the glucose metabolism alteration. HXK2 overexpression (WT + HXK2) and deletion (hxk2Δ or hxk2Δ + HXK2) both resulted in a lower silencing loss rate than observed in the WT strain (Fig. 5A, B). When WT strains were treated with 2-DG to inhibit glycolysis process, the silencing loss rate increased significantly by student t-test (Fig. 5B). In the experiment, we also assessed whether the other Hexokinases deletion mutants (hxk1Δ and glk1Δ) affect chromatin stability. The results show no significant difference between hxk1Δ, glk1Δ, hxk1Δ glk1Δ and WT (Supplemental Fig. 1). In the next step, we perform immunoblot analysis to measure the total level of histone post translation modifications in order to understand the effect of 2-DG on chromatin structure using both yeast and human prostate cancer cells (PC-3). In line with the earlier research, we found that all histone modifications were significantly reduced in HXK2 expression strains with 2-DG treatment [38, 39] comparing to hxk2 deleted yeast cells (Supplemental Fig. 2). We transduced the sh-RNAs to deplete the HK2 levels in prostate cancer cells PC-3 cells as we did before [40]. Knockdown of HK2 levels leads to a significant increase in H3K4me3 and H3K36me3 histone levels (Fig. 5C and D). However, no significant difference was observed between normal and HK2 knockdown cells on both levels of H3K4me3 and H3K36me3 histones under 2-DG treatment condition (Fig. 5C and E). These findings suggest a link between the glycolysis process mediated by HXK2 and chromatin structure. In summary, our results indicate that altered HXK2 levels reduce yeast chromatin instability and 2-DG treatment can increase chromatin instability. They also shed light on the potential of 2-DG to modulate chromatin dynamics in yeast cells, underscoring the multifaceted effects of this glucose metabolism inhibitor on cellular processes.
Fig. 5.
Effect of Hxk levels on loss of silencing at the HML locus. (A) Typical fluorescence images of colonies derived from WT, WT + HXK2, hxk2Δ + HXK2, hxk2Δ yeast strains containing the LoxP-RFP-LoxP-GFP cassette at URA3 locus and a HMLα::cre at the silenced HML locus. The CRASH (Cre-reported altered states of heterochromatin) system [41] was used in this assay. Bright green sectors in GFP channels or dark sectors in RFP channels represent loss of silencing. (B) The WT, WT + HXK2, hxk2Δ + HXK2, and hxk2Δ yeast strains showed different degrees of silencing at the HML locus when analyzed by the CRASH (Cre-reported altered states of heterochromatin) assay. Error bar = standard error. *p < 0.05, **p < 0.01, and ****p < 0.0001 by Student’s t-test. (C) Immunoblot analysis of histone marks H3K4me3 and H3K36me3 from lysates prepared from untreated (left panel) and 2-DG treated (right panel) PC-3 cells transduced with two shRNAs targeting HK2. (D and E) Quantified relative levels of histone marks from panel (C) images using ImageJ.
Impact of HXK2 inhibition on cell cycle progression and the DNA damage response
From the FACS analysis (Fig. 3B and C), HXK2 deletion appears to increase the S phase population. To investigate potential changes in cell cycle cyclin levels, we generated yeast strains with FLAG-tagged CLN2 (G1-S cyclin) and CLB1(G2-M cyclin). The two cyclin levels were measured using Western blot analysis. The results showed that yeast cells lacking HXK2 and wild-type yeast cells exhibited similar levels of CLN2 and CLB1 cyclins (Supplemental Fig. 3). This result may be due to the low sensitivity of the method, which might not be sufficient to detect small differences. To gain further insights into the effects of 2-DG on cell physiology, we assessed its influence on cell cycle progression and its potential to induce systemic DNA damage. First, we investigated the effects of HXK2 inhibition on cell cycle progression. Logarithmically growing yeast cells (both WT and hxk2Δ) were subjected to 2-DG treatment, and we conducted FACS at various time points to measure changes in DNA content. We hypothesized that the cell cycle is predominately arrested at one of cell cycle stages because the glucose metabolism is inhibited. In the WT yeast strain, characterized by normal HXK2 expression, 2-DG treatment predominantly led to cell cycle arrest at the G2 phase (Fig. 6A, B). No significant effects were observed in hxk2Δ yeast cells following 2-DG treatment; the G1 enrichment observed in this strain at the 8-hour time point was attributed to prolonged culture and nutrient depletion.
Fig. 6.
Hxk inhibition arrests yeast cells at G2 phase but does not activate the cell cycle checkpoint. (A-B) Fluorescence-activated cell sorting (FACS) analysis of DNA content in WT and hxk2Δ yeast strains treated with 0.2% 2-deoxy-D-glucose (2-DG, an Hxk2 inhibitor) at different time points. This data indicates that 2-DG treatment leads to more G2 cells. (B) Histograms showing the distribution in the different phases of the cell cycle. (C) Immunoblot analysis of levels of Rad53-P, a cell cycle checkpoint protein and marker of the DNA damage response, in WT and hxk2Δ yeast strains. WT yeast cells before and after treatment with methyl methanesulfonate (MMS; a DNA damaging agent) serve as negative and positive controls, respectively. For 2-DG-treated samples, WT and hxk2Δ cells were treated with 0.2% 2-DG for 2 h
Furthermore, the 2-DG treatment changed the cell cycle progress, which is frequently associated with DNA damage response. We next investigated whether inhibiting HXK2 induced systemic DNA damage. Both γH2A.X and Rad53(vital cell cycle checkpoint protein) are activated and phosphorylated (H2A (p-S139, p-Rad53) in response to DNA replication stress [42]. Thus, phosphorylated H2A and RAD53 indicates a systemic DNA damage response [43]. For instance, exposure to methyl-methanesulfonate induces detectable levels of p-Rad53 (Fig. 6C). We analyzed p-Rad53 levels in strains treated with 2-DG via Western blot analysis. Our results indicate that neither 2-DG-treated WT nor 2-DG-treated hxk2Δ yeast strains displayed activated Rad53 (Fig. 6C). And we analyzed the γH2A.X levels, did not find change in the levels wild type and hxk2Δ yeast strains (Supplemental Fig. 3). These findings suggest that 2-DG-induced cell cycle arrest occurs primarily at the G2 phase but does not lead to widespread DNA damage. These observations provide valuable insights into the specific impact of 2-DG on cell cycle dynamics and establish the absence of a prominent DNA damage response, further contributing to our understanding of the cellular effects of this glycolytic inhibitor.
Discussion
In this study, we explored the impact of altering expression of the glycolytic enzyme HXK2 on parental nucleosome transfer and epigenetic stability in yeast. The nucleosome assembly primary pathway involves in epigenetics inheritance mechanisms. Epigenetic enzymes employ several metabolic intermediates as substrates or co-factors to carry out post-translational modifications of DNA and histones [44], and numerous studies have underscored the crucial role of histone tail acetylation in nucleosome assembly [45, 46]. Disrupting acetylation modifications can result in genome instability [45, 46]. Thus, we hypothesized that altering HXK2 expression might impact glycolysis rates in the cell [47, 48] and thus the cell’s global epigenetic signature and genome stability. However, our findings indicate that changes in HXK expression, whether resulting from overexpression or deletion, have a minimal effect on parental nucleosome assembly and seem to decrease chromatin instability. Surprisingly, inhibiting HXK2 via treatment with 2-DG increased chromatin instability.
These findings imply that in yeast cells with HXK2 deletions, the minimal ATP levels generated through glycolysis, driven by alternative HXKs, such as HXK1 or GLK1, are sufficient to sustain epigenetic stability. Interestingly, recent research has shown that a high-glucose culture medium can enhance chromatin instability, with the NAD-dependent histone deacetylase Sir2 playing a role in this process [49]. It appears that energy source (glucose) availability, rather than enzyme levels, is the primary rate-limiting factor for chromatin stability.
The proliferation of many cancer cells heavily relies on aberrant energy metabolism, such as the Warburg effect or aerobic glycolysis [50]. Therefore, inhibiting Warburg effect has emerged as a potential strategy to target and eliminate tumor cells, with the glycolysis inhibitor 2-DG being one potential candidate drug of this type. As mentioned, our study suggests that 2-DG treatment increases epigenetic instability. However, this effect appears to occur independent of glycolysis inhibition, as lower HXK2 levels increase epigenetic stability. It’s known that 2-DG can drains the cells ATP through accumulation of non-metabolizable 2-DG-6P [51]. As a result of ATP depletion, various cellular processes may be affected, potentially leading to chromatin instability. We measured cellular ATP levels in our strains. Overexpression of HXK2 led to an increase in ATP levels, while chronic 2-DG treatment significantly decreased ATP levels. However, HXK2 deletion did not significantly alter cellular ATP levels. Prolonged, moderate 2-DG treatment resulted in only a slight decrease in ATP levels (Supplemental Fig. 4) [52]. Thus, the precise mechanism underlying 2-DG’s impact on chromatin stability warrants further investigation.
Previous report shows that the human GlkB (hHK4) protein, which has a similar molecular weight as the yeast HXK2 protein, can complement the growth phenotype of a yeast hxk1Δ/hxk2Δ/glk1Δ mutant [53]. Likewise, several plant HXKs have been shown to complement growth phenotypes in yeast HXK mutants [27, 54, 55]. In our experiments, despite effectively functioning yeast HXK1 and HXK2 genes within the same vector, overexpressing the human-derived hHK1 and hHK2 genes did not rescue the growth defect phenotype of a yeast hxk1Δ hxk2Δ mutant. A likely explanation for this outcome is that human HKs are inhibited by their product Glu6P through feedback inhibition. The Glu6P level in yeast cells significantly exceeds the inhibitor constant Ki of hHK1 and hHK2 (0.5–2 mM compared to 0.02 mM, respectively) [2, 56]. Strong evidence supports this explanation is the recent isolated hHK1 and hHK2 mutants, which can bypass these inhibition [57]. However, alternative explanations cannot be entirely ruled out.
Conclusions
Hexokinases (HXKs) are the key enzymes regulating glycolysis in cells. Overexpression of HXKs has been linked to numerous types of cancers and targeting HXKs has been suggested as a potential strategy of cancer therapy. In this study, our result suggests either higher or lower HXKs expression level decreases the chromatin instability. However, 2-Deoxy-D-glucose (2-DG), a HXK inhibitor, treatment cells show increased chromatin instability with unknown mechanisms.
Electronic supplementary material
Below is the link to the electronic supplementary material.
Acknowledgements
We thank Jizhi Ge, and Huipeng Liu for laboratory assistance and Dr. Xia Zhao for biostatistics analysis. We also thank Dr. Zhiguo Zhang for providing the antibodies. We also thank Kristin Harper, PhD, of Harper Health & Science Communications, LLC, for providing editorial support in accordance with Good Publication Practice guidelines.
Author contributions
SK, CY and DY conceived the project and designed the study. SK, CY, JJ and YY performed experiments and data analysis. QD and HG did bioinformatic data analysis. SK, CY, ZZ and HG analyzed the data and interpreted the outcomes. All authors participated in reviewing and interpretation of the data and writing the manuscript. All authors read and approved the final manuscript.
Funding
This work was supported by NIH grant R01GM130588 (to C.Y.), the Hormel Startup Fund, and the National Natural Science Foundation of China (Grants No. 32090031, 32070610, to H.G.).
Data availability
The datasets generated and analyzed during the current study are available in the GEO repository, GSE 245005.
Declarations
Ethics approval and consent to participate
Not applicable.
Consent for publication
Not applicable.
Competing interests
The authors declare no competing interests.
Footnotes
Publisher’s Note
Springer Nature remains neutral with regard to jurisdictional claims in published maps and institutional affiliations.
References
- 1.Lowry OH, Passonneau JV. The relationships between substrates and enzymes of Glycolysis in Brain. J Biol Chem. 1964;239:31–42. 10.1016/S0021-9258(18)51741-5 [DOI] [PubMed] [Google Scholar]
- 2.Wilson JE. Isozymes of mammalian hexokinase: structure, subcellular localization and metabolic function. J Exp Biol. 2003;206(Pt 12):2049–57. 10.1242/jeb.00241 [DOI] [PubMed] [Google Scholar]
- 3.Smith TA. Mammalian hexokinases and their abnormal expression in cancer. Br J Biomed Sci. 2000;57(2):170–8. [PubMed] [Google Scholar]
- 4.Jiang M, Liu S, Lin J, Hao W, Wei B, Gao Y, et al. A pan-cancer analysis of molecular characteristics and oncogenic role of hexokinase family genes in human tumors. Life Sci. 2021;264:118669. 10.1016/j.lfs.2020.118669 [DOI] [PubMed] [Google Scholar]
- 5.Li H, Song J, He Y, Liu Y, Liu Z, Sun W, et al. CRISPR/Cas9 screens reveal that Hexokinase 2 enhances Cancer Stemness and Tumorigenicity by activating the ACSL4-Fatty acid beta-oxidation pathway. Adv Sci (Weinh). 2022;9(21):e2105126. 10.1002/advs.202105126 [DOI] [PMC free article] [PubMed] [Google Scholar]
- 6.Magalhaes RSS, Boechat FC, Brasil AA, Neto JRM, Ribeiro GD, Paranhos LH, et al. Hexokinase 2: the preferential target of trehalose-6-phosphate over hexokinase 1. J Cell Biochem. 2022;123(11):1808–16. 10.1002/jcb.30317 [DOI] [PubMed] [Google Scholar]
- 7.Patra KC, Wang Q, Bhaskar PT, Miller L, Wang Z, Wheaton W, et al. Hexokinase 2 is required for tumor initiation and maintenance and its systemic deletion is therapeutic in mouse models of cancer. Cancer Cell. 2013;24(2):213–28. 10.1016/j.ccr.2013.06.014 [DOI] [PMC free article] [PubMed] [Google Scholar]
- 8.Guo D, Meng Y, Jiang X, Lu Z. Hexokinases in cancer and other pathologies. Cell Insight. 2023;2(1):100077. 10.1016/j.cellin.2023.100077 [DOI] [PMC free article] [PubMed] [Google Scholar]
- 9.Liu Y, Li M, Zhang Y, Wu C, Yang K, Gao S, et al. Structure based discovery of novel hexokinase 2 inhibitors. Bioorg Chem. 2020;96:103609. 10.1016/j.bioorg.2020.103609 [DOI] [PubMed] [Google Scholar]
- 10.Zheng M, Wu C, Yang K, Yang Y, Liu Y, Gao S, et al. Novel selective hexokinase 2 inhibitor Benitrobenrazide blocks cancer cells growth by targeting glycolysis. Pharmacol Res. 2021;164:105367. 10.1016/j.phrs.2020.105367 [DOI] [PubMed] [Google Scholar]
- 11.Thomas GE, Egan G, Garcia-Prat L, Botham A, Voisin V, Patel PS, et al. The metabolic enzyme hexokinase 2 localizes to the nucleus in AML and normal haematopoietic stem and progenitor cells to maintain stemness. Nat Cell Biol. 2022;24(6):872–84. 10.1038/s41556-022-00925-9 [DOI] [PMC free article] [PubMed] [Google Scholar]
- 12.Lesko MA, Chandrashekarappa DG, Jordahl EM, Oppenheimer KG, Bowman RW 2nd, Shang C, et al. Changing course: glucose starvation drives nuclear accumulation of hexokinase 2 in S. Cerevisiae. PLoS Genet. 2023;19(5):e1010745. 10.1371/journal.pgen.1010745 [DOI] [PMC free article] [PubMed] [Google Scholar]
- 13.Walsh RB, Kawasaki G, Fraenkel DG. Cloning of genes that complement yeast hexokinase and glucokinase mutants. J Bacteriol. 1983;154(2):1002–4. 10.1128/jb.154.2.1002-1004.1983 [DOI] [PMC free article] [PubMed] [Google Scholar]
- 14.Clifton D, Walsh RB, Fraenkel DG. Functional studies of yeast glucokinase. J Bacteriol. 1993;175(11):3289–94. 10.1128/jb.175.11.3289-3294.1993 [DOI] [PMC free article] [PubMed] [Google Scholar]
- 15.Yu C, Gan H, Zhang Z. Strand-Specific Analysis of DNA Synthesis and Proteins Association with DNA Replication Forks in Budding Yeast. Methods Molecular Biology. Genome Instability. 1672: Springer Nature; 2018. p. In press. [DOI] [PubMed]
- 16.O’Donnell AF, McCartney RR, Chandrashekarappa DG, Zhang BB, Thorner J, Schmidt MC. 2-Deoxyglucose impairs Saccharomyces cerevisiae growth by stimulating Snf1-regulated and alpha-arrestin-mediated trafficking of hexose transporters 1 and 3. Mol Cell Biol. 2015;35(6):939–55. 10.1128/MCB.01183-14 [DOI] [PMC free article] [PubMed] [Google Scholar]
- 17.Pajak B, Siwiak E, Soltyka M, Priebe A, Zielinski R, Fokt I et al. 2-Deoxy-d-Glucose and its analogs: from Diagnostic to Therapeutic agents. Int J Mol Sci. 2019;21(1). [DOI] [PMC free article] [PubMed]
- 18.Ingram DK, Roth GS. Glycolytic inhibition: an effective strategy for developing calorie restriction mimetics. Geroscience. 2021;43(3):1159–69. 10.1007/s11357-020-00298-7 [DOI] [PMC free article] [PubMed] [Google Scholar]
- 19.Treco DA, Winston F. Growth and manipulation of yeast. Curr Protoc Mol Biol 2008;Chap 13:Unit 13 2. [DOI] [PubMed]
- 20.Gietz RD. Yeast transformation by the LiAc/SS carrier DNA/PEG method. Methods Mol Biol. 2014;1205:1–12. 10.1007/978-1-4939-1363-3_1 [DOI] [PubMed] [Google Scholar]
- 21.Han J, Zhou H, Horazdovsky B, Zhang K, Xu RM, Zhang Z. Rtt109 acetylates histone H3 lysine 56 and functions in DNA replication. Science. 2007;315(5812):653–5. 10.1126/science.1133234 [DOI] [PubMed] [Google Scholar]
- 22.Huang S, Zhou H, Tarara J, Zhang Z. A novel role for histone chaperones CAF-1 and Rtt106p in heterochromatin silencing. EMBO J. 2007;26(9):2274–83. 10.1038/sj.emboj.7601670 [DOI] [PMC free article] [PubMed] [Google Scholar]
- 23.Yu C, Gan H, Serra-Cardona A, Zhang L, Gan S, Sharma S, et al. A mechanism for preventing asymmetric histone segregation onto replicating DNA strands. Science. 2018;361(6409):1386–9. 10.1126/science.aat8849 [DOI] [PMC free article] [PubMed] [Google Scholar]
- 24.Gan H, Serra-Cardona A, Hua X, Zhou H, Labib K, Yu C, et al. The Mcm2-Ctf4-Polalpha Axis facilitates parental histone H3-H4 transfer to lagging strands. Mol Cell. 2018;72(1):140–51. e3. 10.1016/j.molcel.2018.09.001 [DOI] [PMC free article] [PubMed] [Google Scholar]
- 25.Tian C, Zhang Q, Jia J, Zhou J, Zhang Z, Karri S, et al. DNA polymerase delta governs parental histone transfer to DNA replication lagging strand. Proc Natl Acad Sci U S A. 2024;121(20):e2400610121. 10.1073/pnas.2400610121 [DOI] [PMC free article] [PubMed]
- 26.Nelson JD, Denisenko O, Bomsztyk K. Protocol for the fast chromatin immunoprecipitation (ChIP) method. Nat Protoc. 2006;1(1):179–85. 10.1038/nprot.2006.27 [DOI] [PubMed] [Google Scholar]
- 27.Nilsson A, Olsson T, Ulfstedt M, Thelander M, Ronne H. Two novel types of hexokinases in the moss Physcomitrella patens. BMC Plant Biol. 2011;11:32. 10.1186/1471-2229-11-32 [DOI] [PMC free article] [PubMed] [Google Scholar]
- 28.Li Z, Hua X, Serra-Cardona A, Xu X, Zhang Z. Efficient and strand-specific profiling of replicating chromatin with enrichment and sequencing of protein-associated nascent DNA in mammalian cells. Nat Protoc. 2021;16(5):2698–2721. 10.1038/s41596-021-00520-6 [DOI] [PMC free article] [PubMed]
- 29.Langmead B, Salzberg SL. Fast gapped-read alignment with Bowtie 2. Nat Methods. 2012;9(4):357–9. 10.1038/nmeth.1923 [DOI] [PMC free article] [PubMed] [Google Scholar]
- 30.Brogaard K, Xi L, Wang JP, Widom J. A map of nucleosome positions in yeast at base-pair resolution. Nature. 2012;486(7404):496–501. 10.1038/nature11142 [DOI] [PMC free article] [PubMed] [Google Scholar]
- 31.Sheu YJ, Kinney JB, Stillman B. Concerted activities of Mcm4, Sld3, and Dbf4 in control of origin activation and DNA replication fork progression. Genome Res. 2016;26(3):315–30. 10.1101/gr.195248.115 [DOI] [PMC free article] [PubMed] [Google Scholar]
- 32.Soncini SR, Chandrashekarappa DG, Augustine DA, Callahan KP, O’Donnell AF, Schmidt MC. Spontaneous mutations that confer resistance to 2-deoxyglucose act through Hxk2 and Snf1 pathways to regulate gene expression and HXT endocytosis. PLoS Genet. 2020;16(7):e1008484. 10.1371/journal.pgen.1008484 [DOI] [PMC free article] [PubMed] [Google Scholar]
- 33.Blazquez MA, Lagunas R, Gancedo C, Gancedo JM. Trehalose-6-phosphate, a new regulator of yeast glycolysis that inhibits hexokinases. FEBS Lett. 1993;329(1–2):51–4. 10.1016/0014-5793(93)80191-V [DOI] [PubMed] [Google Scholar]
- 34.Fernandez-Garcia P, Pelaez R, Herrero P, Moreno F. Phosphorylation of yeast hexokinase 2 regulates its nucleocytoplasmic shuttling. J Biol Chem. 2012;287(50):42151–64. 10.1074/jbc.M112.401679 [DOI] [PMC free article] [PubMed] [Google Scholar]
- 35.Vega M, Riera A, Fernandez-Cid A, Herrero P, Moreno F. Hexokinase 2 is an intracellular glucose sensor of yeast cells that maintains the structure and activity of Mig1 protein Repressor Complex. J Biol Chem. 2016;291(14):7267–85. 10.1074/jbc.M115.711408 [DOI] [PMC free article] [PubMed] [Google Scholar]
- 36.Bannister AJ, Kouzarides T. Regulation of chromatin by histone modifications. Cell Res. 2011;21(3):381–95. 10.1038/cr.2011.22 [DOI] [PMC free article] [PubMed] [Google Scholar]
- 37.Yu C, Gan H, Han J, Zhou ZX, Jia S, Chabes A, et al. Strand-specific analysis shows protein binding at replication forks and PCNA unloading from lagging strands when forks stall. Mol Cell. 2014;56(4):551–63. 10.1016/j.molcel.2014.09.017 [DOI] [PMC free article] [PubMed] [Google Scholar]
- 38.Cluntun AA, Huang H, Dai L, Liu X, Zhao Y, Locasale JW. The rate of glycolysis quantitatively mediates specific histone acetylation sites. Cancer Metab. 2015;3:10. 10.1186/s40170-015-0135-3 [DOI] [PMC free article] [PubMed] [Google Scholar]
- 39.Jo C, Park S, Oh S, Choi J, Kim EK, Youn HD, et al. Histone acylation marks respond to metabolic perturbations and enable cellular adaptation. Exp Mol Med. 2020;52(12):2005–19. 10.1038/s12276-020-00539-x [DOI] [PMC free article] [PubMed] [Google Scholar]
- 40.Wang L, Xiong H, Wu F, Zhang Y, Wang J, Zhao L, et al. Hexokinase 2-mediated Warburg effect is required for PTEN- and p53-deficiency-driven prostate cancer growth. Cell Rep. 2014;8(5):1461–74. 10.1016/j.celrep.2014.07.053 [DOI] [PMC free article] [PubMed] [Google Scholar]
- 41.Dodson AE, Rine J. Heritable capture of heterochromatin dynamics in Saccharomyces cerevisiae. Elife. 2015;4:e05007. 10.7554/eLife.05007 [DOI] [PMC free article] [PubMed] [Google Scholar]
- 42.Karri S, Yang Y, Zhou J, Dickinson Q, Jia J, Huang Y et al. Defective transfer of parental histone decreases frequency of homologous recombination by increasing free histone pools in budding yeast. Nucleic Acids Res. 2024. [DOI] [PMC free article] [PubMed]
- 43.Sanchez Y, Desany BA, Jones WJ, Liu Q, Wang B, Elledge SJ. Regulation of RAD53 by the ATM-like kinases MEC1 and TEL1 in yeast cell cycle checkpoint pathways. Science. 1996;271(5247):357–60. 10.1126/science.271.5247.357 [DOI] [PubMed] [Google Scholar]
- 44.Assante G, Chandrasekaran S, Ng S, Tourna A, Chung CH, Isse KA, et al. Acetyl-CoA metabolism drives epigenome change and contributes to carcinogenesis risk in fatty liver disease. Genome Med. 2022;14(1):67. 10.1186/s13073-022-01071-5 [DOI] [PMC free article] [PubMed] [Google Scholar]
- 45.Chen CC, Carson JJ, Feser J, Tamburini B, Zabaronick S, Linger J, et al. Acetylated lysine 56 on histone H3 drives chromatin assembly after repair and signals for the completion of repair. Cell. 2008;134(2):231–43. 10.1016/j.cell.2008.06.035 [DOI] [PMC free article] [PubMed] [Google Scholar]
- 46.Li Q, Zhou H, Wurtele H, Davies B, Horazdovsky B, Verreault A, et al. Acetylation of histone H3 lysine 56 regulates replication-coupled nucleosome assembly. Cell. 2008;134(2):244–55. 10.1016/j.cell.2008.06.018 [DOI] [PMC free article] [PubMed] [Google Scholar]
- 47.Liang Q, Donthi RV, Kralik PM, Epstein PN. Elevated hexokinase increases cardiac glycolysis in transgenic mice. Cardiovasc Res. 2002;53(2):423–30. 10.1016/S0008-6363(01)00495-3 [DOI] [PubMed] [Google Scholar]
- 48.DeWaal D, Nogueira V, Terry AR, Patra KC, Jeon SM, Guzman G, et al. Hexokinase-2 depletion inhibits glycolysis and induces oxidative phosphorylation in hepatocellular carcinoma and sensitizes to metformin. Nat Commun. 2018;9(1):446. 10.1038/s41467-017-02733-4 [DOI] [PMC free article] [PubMed] [Google Scholar]
- 49.McCleary DF, Rine J. Nutritional Control of Chronological Aging and Heterochromatin in Saccharomyces cerevisiae. Genetics. 2017;205(3):1179–93. 10.1534/genetics.116.196485 [DOI] [PMC free article] [PubMed] [Google Scholar]
- 50.Vander Heiden MG, Cantley LC, Thompson CB. Understanding the Warburg effect: the metabolic requirements of cell proliferation. Science. 2009;324(5930):1029–33. 10.1126/science.1160809 [DOI] [PMC free article] [PubMed] [Google Scholar]
- 51.Laussel C, Leon S. Cellular toxicity of the metabolic inhibitor 2-deoxyglucose and associated resistance mechanisms. Biochem Pharmacol. 2020;182:114213. 10.1016/j.bcp.2020.114213 [DOI] [PubMed] [Google Scholar]
- 52.Ozalp VC, Pedersen TR, Nielsen LJ, Olsen LF. Time-resolved measurements of intracellular ATP in the yeast Saccharomyces cerevisiae using a new type of nanobiosensor. J Biol Chem. 2010;285(48):37579–88. 10.1074/jbc.M110.155119 [DOI] [PMC free article] [PubMed] [Google Scholar]
- 53.Mayordomo I, Sanz P. Human pancreatic glucokinase (GlkB) complements the glucose signalling defect of Saccharomyces cerevisiae hxk2 mutants. Yeast. 2001;18(14):1309–16. 10.1002/yea.780 [DOI] [PubMed] [Google Scholar]
- 54.Jang JC, Leon P, Zhou L, Sheen J. Hexokinase as a sugar sensor in higher plants. Plant Cell. 1997;9(1):5–19. [DOI] [PMC free article] [PubMed] [Google Scholar]
- 55.Veramendi J, Roessner U, Renz A, Willmitzer L, Trethewey RN. Antisense repression of hexokinase 1 leads to an overaccumulation of starch in leaves of transgenic potato plants but not to significant changes in tuber carbohydrate metabolism. Plant Physiol. 1999;121(1):123–34. 10.1104/pp.121.1.123 [DOI] [PMC free article] [PubMed] [Google Scholar]
- 56.Lagunas R, Gancedo C. Role of phosphate in the regulation of the Pasteur effect in Saccharomyces cerevisiae. Eur J Biochem. 1983;137(3):479–83. 10.1111/j.1432-1033.1983.tb07851.x [DOI] [PubMed] [Google Scholar]
- 57.Boonekamp FJ, Knibbe E, Vieira-Lara MA, Wijsman M, Luttik MAH, van Eunen K, et al. Full humanization of the glycolytic pathway in Saccharomyces cerevisiae. Cell Rep. 2022;39(13):111010. 10.1016/j.celrep.2022.111010 [DOI] [PubMed] [Google Scholar]
Associated Data
This section collects any data citations, data availability statements, or supplementary materials included in this article.
Supplementary Materials
Data Availability Statement
The datasets generated and analyzed during the current study are available in the GEO repository, GSE 245005.